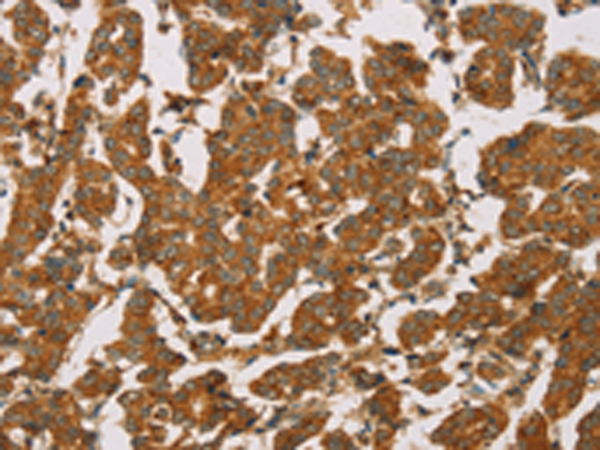

-
分类: 科研抗体货号: P08253别名:应用: IHC反应种属: Human
-
分类: 科研抗体货号: P08232别名: FLAME3; FLAME-3应用: IHC反应种属: Human, Mouse
-
分类: 科研抗体货号: P08211别名: DOC2; DOC-2应用: WB,IHC反应种属: Human, Mouse, Rat
-
分类: 科研抗体货号: P08230别名: CT13; HAGE应用: WB,IHC反应种属: Human
-
分类: 科研抗体货号: P08251别名: NEDD3应用: WB,IHC反应种属: Human, Mouse
-
分类: 科研抗体货号: P08210别名: CYB5; MCB5应用: WB,IHC反应种属: Human, Mouse, Rat
-
分类: 科研抗体货号: P08229别名: DBP5; RNAh; DDX19应用: WB,IHC反应种属: Human
-
分类: 科研抗体货号: P08250别名: DR6; CD358; BM-018应用: IHC反应种属: Human, Mouse, Rat
-
分类: 科研抗体货号: P08227别名: Dig2; REDD1; REDD-1应用: WB,IHC反应种属: Human, Mouse, Rat
-
分类: 科研抗体货号: P08242别名: AOS6; delta4; hdelta2应用: IHC反应种属: Human, Mouse

鄂公网安备42018502007531号
鄂公网安备42018502007531号

